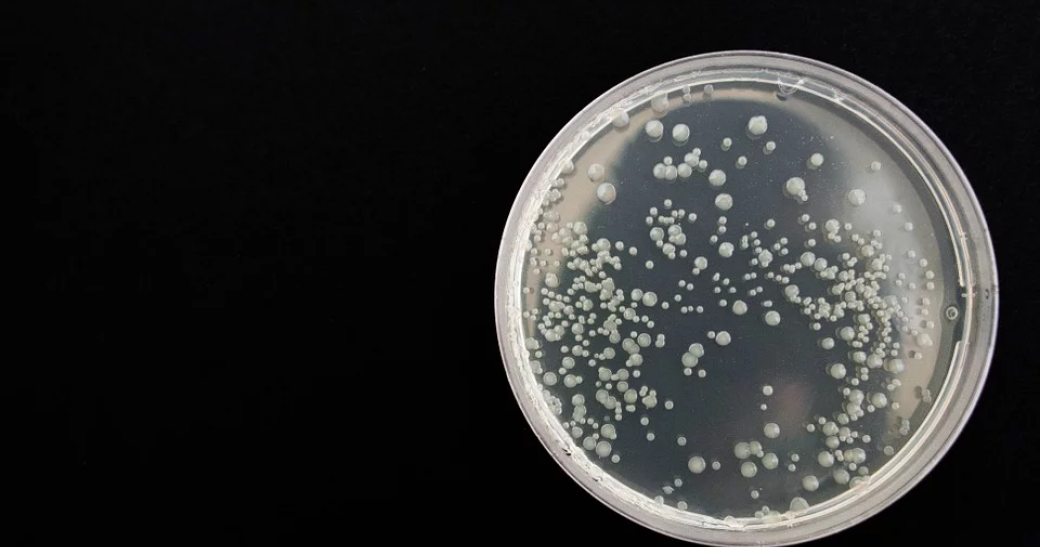

16 marca tego roku Amerykańskie Centrum Zwalczania i Zapobiegania Chorobom (CDC) odnotowało 53 przypadki zakażenia drożdżakami Candida auris oraz 27 przypadków nosicielstwa u osób zdrowych na terenie Stanów Zjednoczonych.
Infekcję C. auris po raz pierwszy zaobserwowano w 2009 r. w Japonii. Od tamtego czasu raportowano zachorowania w 15 krajach, ostatnio jednak odnotowano znaczny skok liczby zakażeń. Drożdżak ten powoduje infekcje układu krwionośnego, ran oraz uszu. Może też doprowadzić do zaburzenia prawidłowych funkcji narządów. Nie istnieją dokładne dane dotyczące liczby zachorowań, ale szacuje się, że śmiertelność może sięgać nawet 60%.
Problem jest złożony. Drożdżaki C. auris wykazują oporność na terapię najważniejszymi lekami przeciwgrzybiczymi. Ponadto lekarze mają problem z odróżnieniem ich przy pomocy standardowych metod laboratoryjnych od innych szczepów Candida.
Największe zagrożenie drożdżaki Candida auris stanowią dla osób z obniżoną odpornością: wcześniaków, cukrzyków, pacjentów dializowanych oraz tych świeżo po przeszczepach i innych zabiegach chirurgicznych. Pozostali pacjenci oraz zdrowi znajdują się w grupie mniejszego ryzyka.
Źródło: https://www.cdc.gov/fungal/diseases/candidiasis/candida-auris.html

 Nasze magazyny
Nasze magazyny